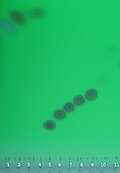

<nowiki>aditivo alimentario; bahan tambahan makanan; Хранителна добавка; Aditiv alimentar; 食品添加物; Prídavná látka v potravinách; харчові додатки; Iýmitlik goşundylar; Афзуданиҳои ғизоӣ; Nutrivala adicioneso; 식품 첨가물; manĝa aldonaĵo; přídatná látka; Prehrambeni aditivi; খাদ্যে সংযোজনদ্রব্য; additif alimentaire; prehrambeni aditivi; phụ gia thực phẩm; pārtikas piedeva; прехрамбени адитив; 食品添加剂; Liewensmëttelzousätz; tilsetjingsstoff; tilsetningsstoff; Aditif kadaharan; food additive; مضاف غذائي; ߛߎ߬ߡߊ߲߬߬ ߠߊ߬ߞߍ; 食物添加劑; Тамак кошумчалары; elikagai-gehigarri; пищевая добавка; аҙыҡ өҫтәмәләре; ychwanegyn bwyd; Shtuesi ushqimor; սննդային հավելում; 食品添加剂; tilsætningsstof; 食品添加物; תוסף מזון; азык өстәмәләре; खाद्य योगज; lisäaine; additivo alimentare; 食品添加物; 食品添加剂; Prehrambeni aditivi; Toidulisaained; 食品添加物; азык өстәмәләре; Prehrambeni aditiv; харчовы дадатак; 食品添加剂; livsmedelstillsats; aditivo alimentar; Lebensmittelzusatzstoff; прехранбен адитив; Прехрамбени адитиви; maisto priedas; prehranski dodatek; élelmiszer-adalékanyag; Aditif makanan; gıda katkısı; วัตถุเจือปนอาหาร; dodatek do żywności; Хүнсний нэмэлт бүтээгдэхүүн; voedingsadditief; breiseán bia; افزودنیهای غذایی; харчовыя дабаўкі; πρόσθετο τροφίμων; aditivo alimentario; additiu alimentari; aditivo ałimentar; Qida əlavələri; ߓߐ߬ߓߐ ߡߍ߲ ߠߎ߬ ߦߋ߫ ߞߍ߫ ߟߊ߫ ߛߎ߬ߡߊ߲ ߠߊ߫; produits ajoutés aux denrées alimentaires commerciales; вещество, добавляющееся в технологических целях в пищевые продукты для придания им желаемых свойств; Verbindungen, die Lebensmitteln zur Erzielung chemischer, physikalischer oder auch physiologischer Effekte zugegeben werden; snov, ki se uporablja v živilski industriji pri pripravi, skladiščenju in trženju živil; 食品に添加する物質; stof die om technische redenen wordt toegevoegd aan een voedingsmiddel; bahan yang ditambahkan ke dalam olahan makanan; substancja chemiczna dodawana do żywności w celu uzyskania określonych pożądanych efektów; สารใด ๆ ที่ถูกเพิ่มลงในอาหารเพื่อการเก็บรักษากลิ่นรส ลักษณะ หรือคุณภาพอื่น ๆ ของอาหาร; istehsal, qablaşdırma, daşınma və ya saxlama zamanı qida məhsullarına texnoloji məqsədlər üçün əlavə olunan maddələr, istədiyiniz xüsusiyyətləri vermək üçün, məsələn, müəyyən bir aroma (ləzzət), rəng (boyalar), raf ömrü (konservantlar), dadı, tutarlı; 植物油(氫化椰子油、氫化棕櫚仁油)、麵粉、砂糖、奶粉、麥芽糖、乳清粉、小麥澱粉、糊精、乳糖、聚糊精、甜味劑(D-木醣醇)、草莓粉(乳糖、草莓粉、微結晶狀a-纖維素、二氧化矽、抗氧化劑(維生素C)、DL蘋果酸、檸檬酸、香料、食用紅色四十號鋁麗基、食用紅色七號鋁麗基、食用黃色五號鋁麗基)、乾燥草莓、可可脂、卵磷脂、奶油、香料、黃豆粉(非基因改造)、檸檬酸鈉鈉、膨鬆劑(碳酸氫鈉); भोजन में मिलाए जाने वाले पदार्थ; sustancia que se añade a alimentos y bebidas; ruokaan lisättävä aine; substances added to food; sostanza impiegata nell'industria alimentare durante la preparazione, lo stoccaggio e la commercializzazione di prodotti destinati all'alimentazione; 가공식품에 특별한 목적을 가지고 사용되는 것; gıdaya eklenen maddeler; Aditivos alimentarios; aditivo alimenticio; aditivo de comida; aditivos de comida; élelmiszer-adalék; bahan tambah; ychwanegion bwyd; breiseán; افزودنی های غذایی; Хранителни добавки; Адитив; Tilsætningsstoffer; gıda katkı maddesi; 添加物; Potravinová prídavná látka; Potravinárska prídavná látka; Prídavná látka do potravín; Aditívum v potravinách; Potravinové aditívum; Potravinárska prísada; Potravinové aditíva; Potravinárske aditíva; Potravinárske aditívum; Potravinová prísada; харчові добавки; харчова добавка; біологічно активна харчова добавка; 식품첨가물; E kód; Éčka; potravinářská aditiva; potravinářské aditivum; additivi alimentari; additifs alimentaires; E-ained; Toidulisaaine; E-aine; Toidu lisaained; Aditivo Químico; Aditivos alimentares; pārtikas piedevas; e-viela; piedeva; Maisto priedai; aditiv; prehranski aditiv; živilski dodatek; aditiv za živila; elintarvikelisäaineet; elintarvikelisäaine; lisäaineet; Aditivi alimentari; Zusatzsstoffe; Lebensmittelzusatz; Nahrungsmittelzusatzstoff; Lebensmittelzusatzstoffe; Nahrungsmittelzusatzstoffe; Fremde Stoffe; aditivo; tilsettingsstoff; Dijetarni suplement; 食品添加劑; 食品添加物; 食品添加; 食物添加劑; пищевые добавки; dodatki do żywności; chemiczny dodatek do żywności; chemiczne dodatki do żywności; Additius; Additiu; Additius alimentaris; חומרים מוספים למזון; תוספי מזון; food additives; E numbers; المواد الحافظة; المواد المضافة للطعام; المضافات الغذائية; aditivi; прехранбени адитиви; прехрабени додатоци; прехрабен додаток</nowiki>
food additive substances added to food |
| Upload media |
|
| Subclass of | |
|---|
|
|